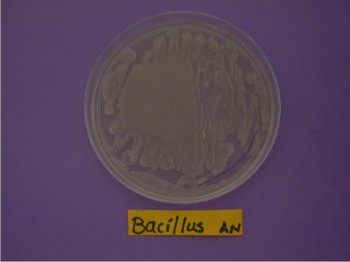

En la primera etapa de proyecto, se están seleccionando aislados rizosféricos de Pseudomonas, Bacillus y de algunos hongos que muestren actividad antagonista in vitro contra el hongo patógeno del garbanzo Fusarium oxysporum f. sp. ciceris raza 5
Fundación Produce Sinaloa, A.C., apoya en el presente ejercicio el proyecto Selección in vitro de microorganismos antagonistas a la raza 5 de Fusarium oxysporum f. sp. ciceris, agente causal de marchitez en el garbanzo cultivado en Sinaloa.
Los objetivos principales del proyecto son:
? Obtener aislados rizosféricos (la rizosfera es una parte del suelo inmediata a las raíces, donde tiene lugar una interacción dinámica con los microorganismos) de Pseudomonas y de Bacillus con base en su potencial antagonista in vitro (en laboratorio) contra la raza 5 de Fusarium oxysporum f. sp. ciceris.
? Obtener aislados fúngicos (referente a hongos) rizosféricos en base a su potencial antagonista in vitro contra la raza 5 de Fusarium oxysporum f. sp. ciceris.
Es necesario realizar más investigación para encontrar estrategias sustentables de control biológico, utilizando microorganismos bacterianos benéficos
El garbanzo últimamente se ha visto afectado por serios problemas de enfermedades que han afectado su rendimiento, siendo imprescindible ??dada su importancia social y económica para Sinaloa?? definir esquemas de control de los agentes más agresivos en la marchitez y amarillamiento del cultivo, en concreto de la raza 5 de Fusarium oxysporum f. sp. ciceris (se ha estimado que esta enfermedad tiene un impacto de disminución de entre 10 y 60 % del rendimiento, siendo uno de los principales factores que limitan la producción).
Para confrontar esta enfermedad y minimizar el uso de químicos en el control del patógeno, y sus negativos efectos ambientales y en la salud humana, se debe realizar más investigación, con el fin de encontrar estrategias sustentables para el control biológico utilizando microorganismos benéficos de naturaleza bacteriana.
Este proyecto está programado en tres fases: en la primera se seleccionarán aislados de microorganismos antagonistas contra la raza 5 de Fusarium oxysporum f. sp. ciceris, en pruebas in vitro. La evaluación en planta, así como la formulación de un biofungicida con base en los microorganismos antagonistas seleccionados y su validación en campo se realizarán en la segunda y tercera fase.
Las especies de Fusarium ocasionan enfermedades como la marchitez vascular y pudrición radicular
Entre las plagas y enfermedades que afectan al garbanzo destacan algunos hongos que ocasionan la rabia o secadera, como Rhizoctonia solani, Macrophomina phaseolina, Sclerotium rolfsii, Fusarium solani y Fusarium oxysporum f. sp. ciceris, que a partir del suelo infectan tejido y follaje, repercutiendo en la producción.
Se ha reportado que las especies de Fusarium ocasionan enfermedades como la marchitez vascular y pudrición radicular; este hongo, al infectar las raíces, se desparrama lentamente a lo largo de los haces vasculares por crecimiento hifal (las hifas son elementos filamentosos cilíndricos característicos de la mayoría de los hongos) y causa necrosis (muerte del tejido), amarillamiento y marchitez de las hojas y tallos.
Ante esta problemática surge la necesidad de encontrar agentes de biocontrol para contrarrestar los efectos de ese patógeno; tal es el caso de la selección de especies de Pseudomonas, Bacillus y algunos hongos, para la producción de agrobiológicos microbianos que impliquen bajos costos y garanticen la preservación de los ecosistemas.
Se han hecho ensayos de antibiosis (asociación entre organismos que resulta dañina para uno de ellos) in vitro en medios artificiales que son determinantes para pasar a una fase de cámaras de crecimiento o invernadero, posteriormente a una fase de pruebas de campo, y finalmente a pruebas de validación en parcelas demostrativas.
En Sinaloa, aunque se han realizado trabajos de investigación para el control biológico de Fusarium en diversos cultivos, aun no son suficientes, puesto que se siguen aplicando químicos, que generan contaminación y daños a la salud, por lo que se requiere generar opciones más amigables de control.
Especies de Bacillus, Pseudomonas y de algunos hongos como Trichoderma, han mostrado ser inhibitorias al crecimiento de diversos hongos fitopatógenos
Pero para poder utilizar estos como agentes efectivos de biocontrol en Sinaloa se requiere contar con una colección de organismos potenciales, caracterizados en su morfología, conducta bioquímica, tasas poblacionales, y con pruebas in vitro y en planta.
El aislamiento de organismos microbianos con potencial antagonista, adaptados a la rizosfera del garbanzo permitirá en un futuro inmediato tener acceso a un sistema tecnológico alternativo que facilitará la utilización de esos microorganismos nativos para estimular el desarrollo del cultivo, con la seguridad de que las poblaciones microbianas colonizarán, sobrevivirán y proliferarán rápidamente, llevando así un mejor beneficio socioambiental y generando mejoras en la calidad de vida en las comunidades agrícolas.
¿En qué consiste el tejido vascular de las plantas?
Está presente en todas las plantas superiores. Está formado por el xilema y el floema. El xilema es una estructura que transporta a través de la planta agua y sales minerales disueltas. El floema transporta nutrientes ya elaborados por las células y por fotosíntesis.
Información proporcionada por Rogelio Sosa Pérez, responsable del proyecto y perteneciente al Centro de Ciencias de Sinaloa. Este proyecto es apoyado por FPS, a través de su Consejo Consultivo zona centro.
En la primera etapa de proyecto, se están seleccionando aislados rizosféricos de Pseudomonas, Bacillus y de algunos hongos que muestren actividad antagonista in vitro contra el hongo patógeno del garbanzo Fusarium oxysporum f. sp. ciceris raza 5